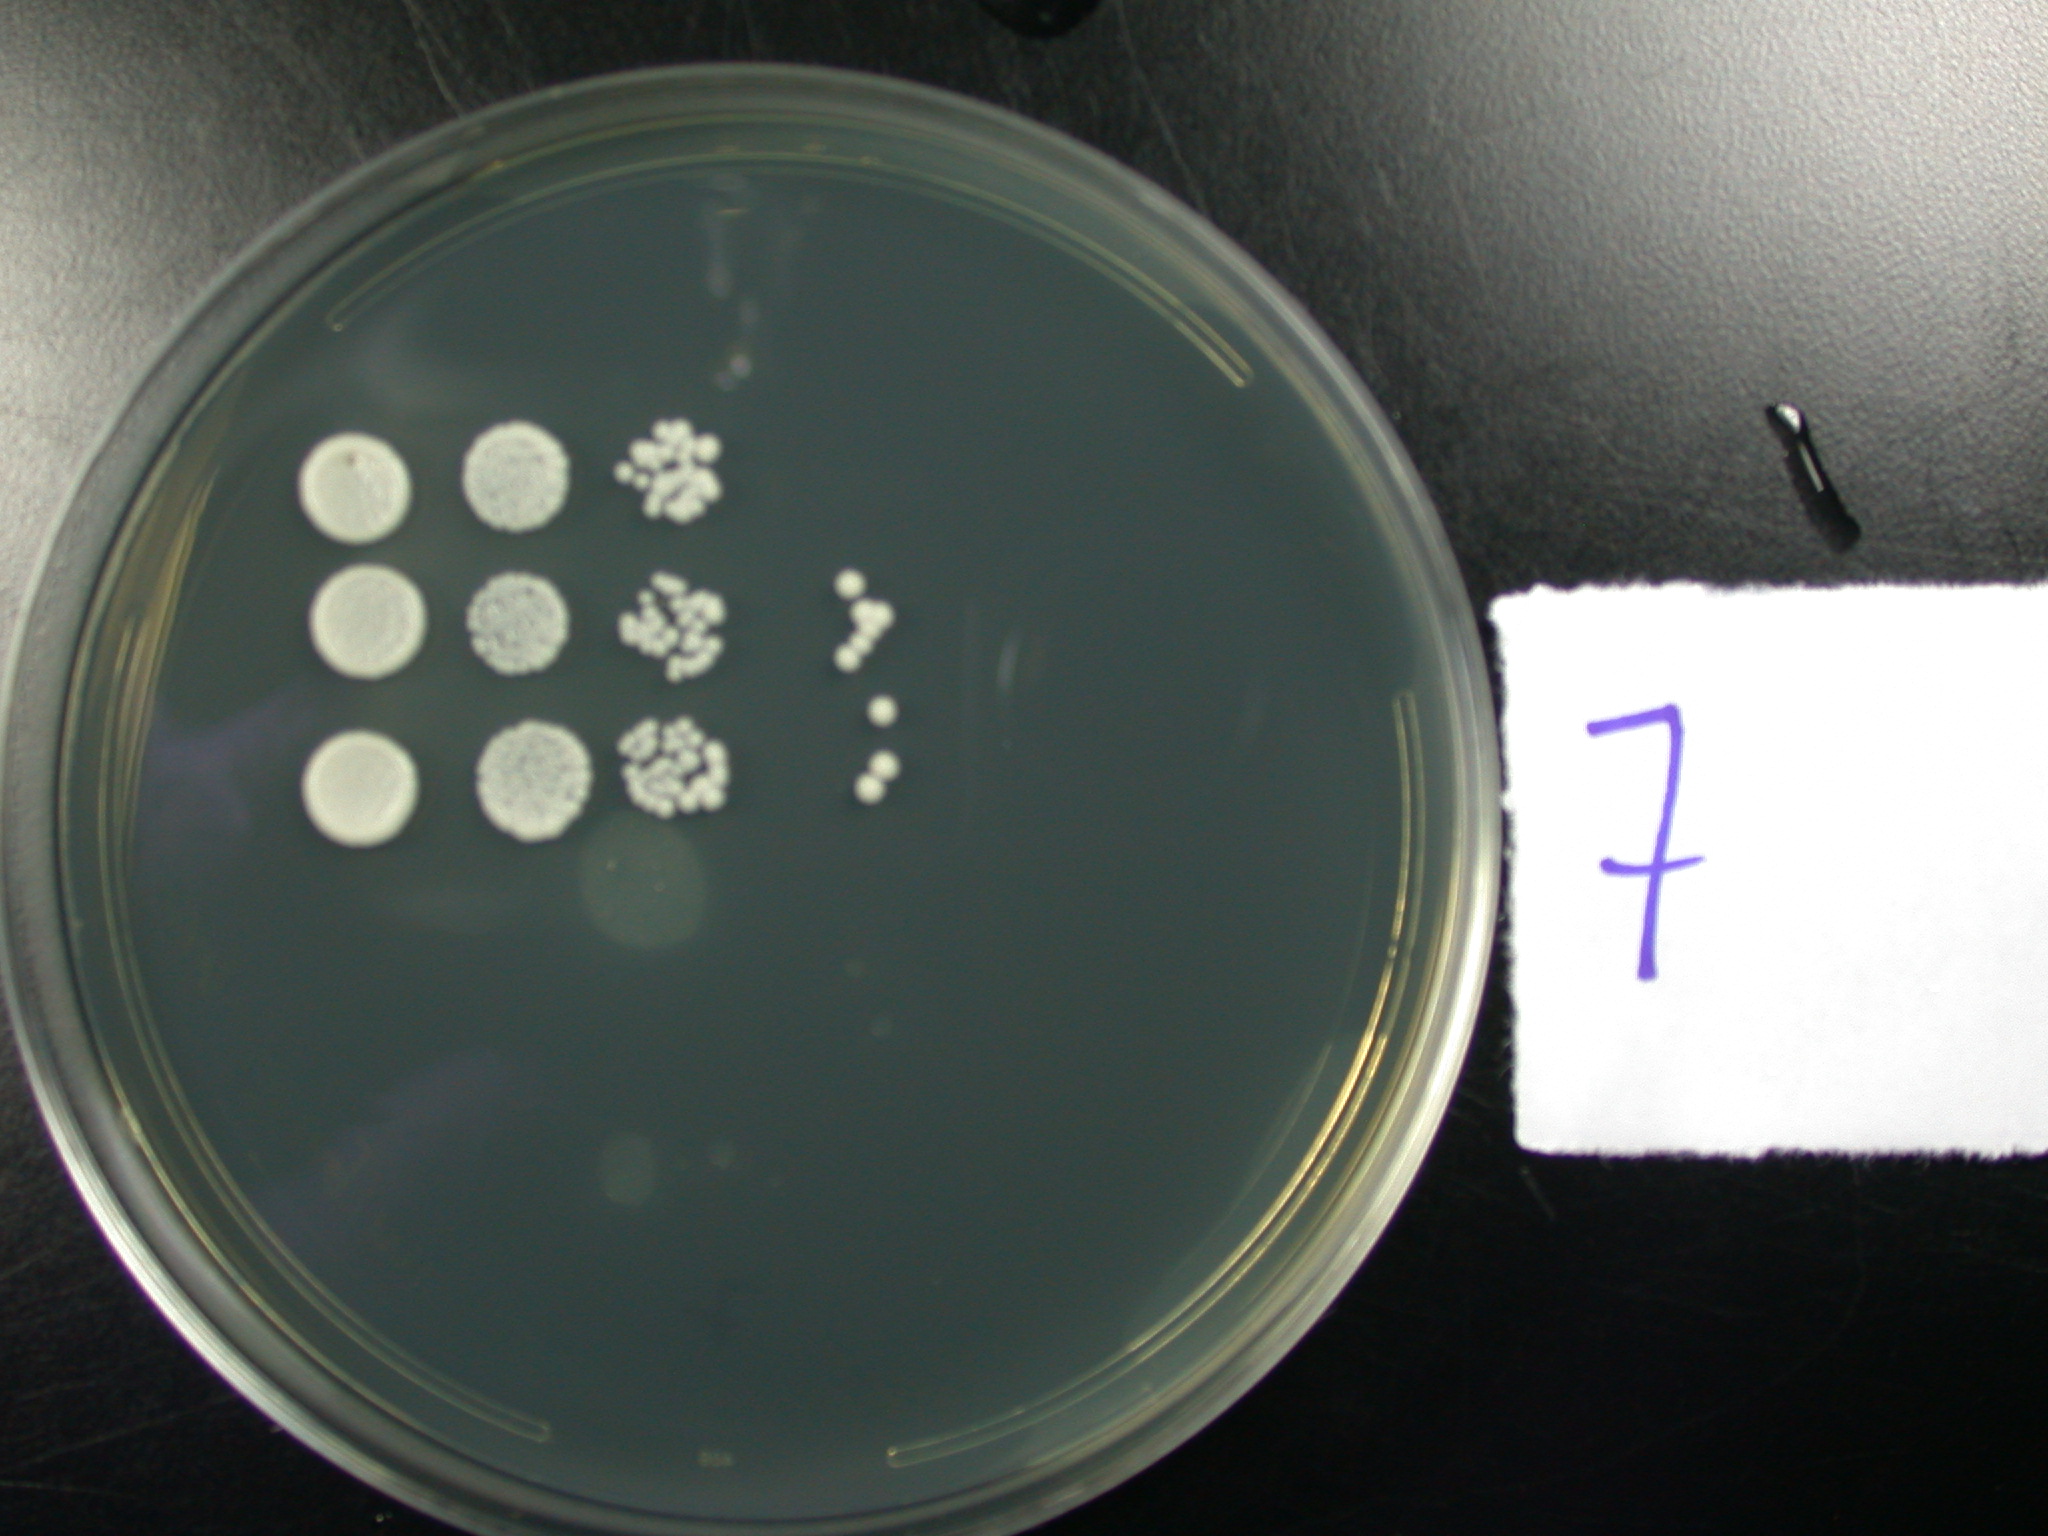

Product Item: Spot plating shop
Spot plating technique to quantify bacterial numbers. This fi gure shop, Time saving Serial Dilution Preparation and Spot Plating shop, DEVELOPMENT OF A SPOT TITER CULTURE ASSAY FOR QUANTIFYING BACTERIA shop, Spot plate Wikipedia shop, Optimization of single plate serial dilution spotting SP SDS shop, Speeding up and greening up bacteria culture count methods shop, Solving problems with spot Ag plating shop, 4.5 Exercise 2 Spot plates Biology LibreTexts shop, Spot plating and simplified reflection based measurement shop, Yeast Spotting Assay Get Your Science On Wiki Fandom shop, Optimization of single plate serial dilution spotting SP SDS shop, Spot tests past and present ChemTexts shop, Student shop, 3 Well Porcelain Slide Micro Spot Plate shop, Spot test of microplate contents. a Plate for spot tests of ASL shop, Gold Spot Plating Equipment spcprecision shop, Spot Inoculation of a Plate from Broth shop, Spot Plate 6 Wells 4 shop, Hyperoxia sensitivity screen spot tests The indicated yeast shop, File Spot plate big wells.jpeg Wikipedia shop, Business Overview ALF TECHNO CO. LTD shop, Spot plate icon outline Royalty Free Vector Image shop, Porcelain Spot Plate shop, Spot Plate 12 Wells 4.6L x 3.5W x 0.4H Polyethylene Plastic Eisco Labs shop, Spot plate assay for SR7 and SR7 gcr2 grown on glucose A and shop, Spot Test Results Titer Calculations Archived and DNA Extraction shop, Serology Cavity Spot Plate Medpip shop, Spot Plate 12 Wells 4.6 shop, YtfK activates the stringent response by triggering the alarmone shop, Solved METHODS 1. Prepare a ceramic spot plate for the Chegg shop, Spot Plating Drum spcprecision shop, Spot plate Sciencemadness Wiki shop, QWORK Spot Plate 4 Pack 6 Wells Porcelain Spotting Reaction shop, Disposable Spot Plate PK 15 American Scientific shop, Optimization of single plate serial dilution spotting SP SDS shop.
Spot plating shop